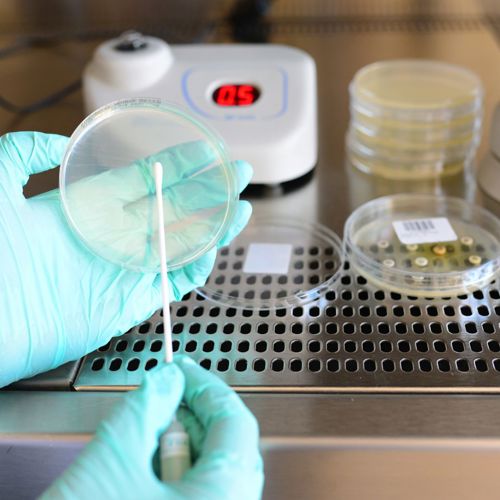

Bacteria is present in all businesses, homes and outdoor spaces. For the most part, bacteria can be beneficial. For example, good bacteria can promote positive gut health and boost immunity. However, bad bacteria, like that often found on infectious persons or in expired food, can cause widespread diseases.
Therefore, it’s important that all people have a good understanding of bacteria, when they can be bad, and what it takes to eliminate them. At Rubbermaid Commercial Products, we’re passionate about helping businesses and homes maintain infection-free premises at all times. Therefore, the following blog showcases what the implications are of harmful bacteria and what can be done to ensure that only good bacteria flow through a business, regardless of the industry it operates in. 
Bacteria Facts: Bacteria can cause infectious outbreaks
As witnessed throughout the COVID pandemic, when bacteria become uncontrollable, they can spread from person to person incredibly quickly. The result of this is a widespread illness. In business settings, this can take many employees out of work, which can put pressure on profits. In worst-case scenarios, when employees may be working when infectious, this can also infect patrons and stimulate negative opinions about a business. This was seen predominately through aged care during COVID, when many companies received a bad reputation as it became clear that cleaning protocols were not well-established.
It is important to note that without constant cleaning, bacteria can never be 100% eradicated. Though there are many things business owners and their staff can do to prevent outbreaks. This includes cleaning regularly, using the right cleaning equipment and promoting healthy behaviours, such as hand washing.
Using the Rubbermaid Cleaning Products range, including the material handling range, aims to help cleaning staff ensure that the interior and exterior of a business are cleaned effectively. The tools are also used to prevent cross-contamination between dirty and clean supplies, such as linen, to guarantee the highest level of cleanliness at all times.
Bacteria Facts: Bacteria can contaminate food and water
Many people are aware of foodborne diseases and how using airtight containers and colour-coded systems can prevent them. However, water-borne diseases are a less addressed issue when bacteria is concerned. Flushing the wrong products into sinks or having damaged plumbing in a business can increase the chances that dangerous matter, such as faecal or animal waste, can end up in the water supply.
It is, therefore, important that businesses take all precautions to ensure that they are not potentially contaminating their guests. Frequent plumbing checks, water filtration systems and using separate sinks for dirty and clean water are all ways water contamination can be prevented.
It’s also important to remember that water can be contaminated through ice cubes. Ensuring that the ice scoop used by a business’s restaurant is kept away from contaminated surfaces and hands can avoid this method of contamination.
Bacteria Facts: Bacteria can cause antibiotic resistance
Though it is not as common as causing sickness or contaminating food and water, bacteria can cause antibiotic resistance. This effect can be incredibly damaging, especially in hospitals where patients may be immune-compromised. Essentially, as bacteria grow and learn about their environment, they can mutate, just like the COVID virus did several times. This mutation makes them more powerful against antibiotics.
It is the primary reason why new flu vaccinations are made each year and why some people may still get chicken pox, even if they have been vaccinated against it.
There isn’t much telling when bacteria will mutate, as it can happen suddenly. However, having a system that eliminates bacteria quickly and efficiently from premises can prevent this mutation from occurring altogether. All businesses should have a detailed cleaning schedule available for all rooms. This list must detail everything that must be cleaned, as well as how often it requires cleaning. For example, a handrail will require much more frequent sanitisation than the ceiling as it is a more in-demand touch point.
There are many tools available for businesses to clean these surfaces in their business. Though, the Rubbermaid HYGEN cleaning range has been innovated for over 60 years. Due to this, it can pick up over 99% of bacteria from a surface. As an added benefit, its fibres also trap bacteria, meaning it can not escape after cleaning. Launderable options are also available to cut down on damage to the environment and act in line with the sustainability mission of businesses. 
Bacteria Facts: Bacteria can be controlled
Bacteria grows rapidly and can begin spreading on a surface from the moment it is cleaned and sanitised. Though it may be impossible to have completely bacteria-free premises, business owners must know that bacteria can be controlled. As mentioned above, the following tools and practices can help reduce the implications of bacteria and prevent seriously negative impacts. Though, countless tools can be utilised to guarantee that harmful bacteria are always kept at a minimum.
Fortunately, the Rubbermaid Commercial Products team are experts at understanding these benefits and can help you learn about the best tools for your business. Get in touch with them today to get started.